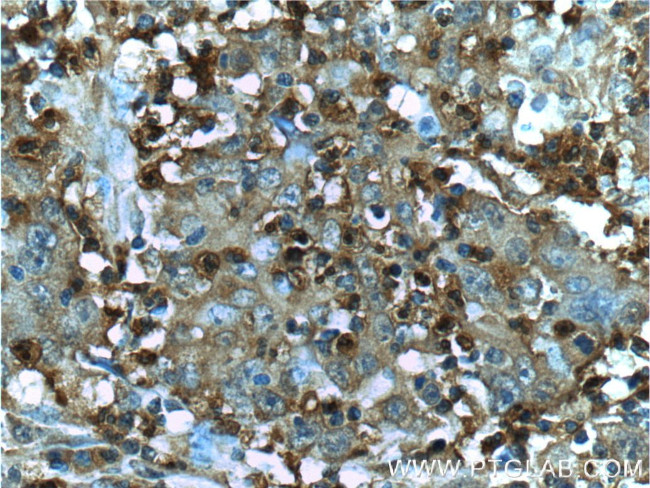
S100A12 Antibody in Immunohistochemistry (Paraffin) (IHC (P))

Search
Proteintech
S100A12 Polyclonal Antibody
{{$productOrderCtrl.translations['antibody.pdp.commerceCard.promotion.promotions']}}
{{$productOrderCtrl.translations['antibody.pdp.commerceCard.promotion.viewpromo']}}
{{$productOrderCtrl.translations['antibody.pdp.commerceCard.promotion.promocode']}}: {{promo.promoCode}} {{promo.promoTitle}} {{promo.promoDescription}}. {{$productOrderCtrl.translations['antibody.pdp.commerceCard.promotion.learnmore']}}
产品信息
16630-1-AP
种属反应
宿主/亚型
分类
类型
抗原
偶联物
形式
浓度
规格
纯化类型
保存液
内含物
保存条件
运输条件
产品详细信息
Immunogen sequence: MTKLEEHLE GIVNIFHQYS VRKGHFDTLS KGELKQLLTK ELANTIKNIK DKAVIDEIFQ GLDANQDEQV DFQEFISLVA IALKAAHYHT HKE (1-92 aa encoded by BC070294)
靶标信息
S100A12 is a member of the S100 family of proteins containing 2 EF-hand calcium-binding motifs. S100 proteins are localized in the cytoplasm and/or nucleus of a wide range of cells, and involved in the regulation of a number of cellular processes such as cell cycle progression and differentiation. S100A12 is proposed to be involved in specific calcium-dependent signal transduction pathways and its regulatory effect on cytoskeletal components may modulate various neutrophil activities. S100A12 is also a ligand for RAGE. Interaction with RAGE on mononuclear phagocytes, lymphocytes and endothelium triggers cellular activation. Nuclear factor kappa B, a key transcription factor for inflammatory events, is activated by S100A12/RAGE. S100A12 has also been shown to have anti-microbial properties.
仅用于科研。不用于诊断过程。未经明确授权不得转售。
生物信息学
蛋白别名: CAAF1; CAGC; calcitermin; Calcium-binding protein in amniotic fluid 1; calgranulin C; Calgranulin-C; CGRP; EN RAGE; EN-RAGE; Extracellular newly identified RAGE-binding protein; Migration inhibitory factor-related protein 6; MRP-6; Neutrophil S100 protein; Protein S100 A12; Protein S100-A12; S100 calcium-binding protein A12
基因别名: CAAF1; CAGC; CGRP; ENRAGE; MRP-6; MRP6; p6; S100A12
UniProt ID: (Human) P80511
Entrez Gene ID: (Human) 6283